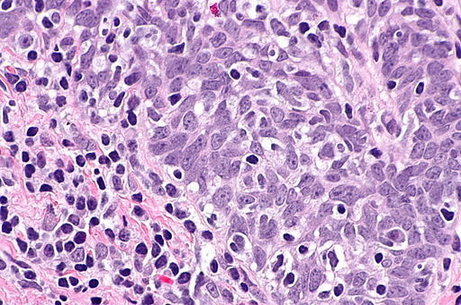

New research which aims to uncover genetic strategies for fighting the growth of cancer cells that have spread from a tumour in the head and neck has been published in the journal Cell Reports this month.
New research which aims to uncover genetic strategies for fighting the growth of cancer cells that have spread from a tumour in the head and neck has been published in the journal Cell Reports this month.
The research by Nathan Benaich [2010] is based on his PhD in Oncology, following an MPhil in Biological Science [Genetics]. It focuses on head and neck squamous cell carcinoma (HNSCC) which receives little attention in the cancer research community despite its increasing incidence and a stagnant five-year survival rate of approximately 50%. In fact, HNSCC is the sixth most common form of cancer worldwide.
Nathan says: “Although our knowledge of the genetics that cause cancer has evolved significantly in recent years, we’re still largely incapable of treating cancer once it has spread around the body. This fatal step in cancer progression, a complex process called metastasis, accounts for over 90% of human solid cancer-related deaths. Indeed, when cancer cells spread beyond the breast, for example, they grow in the brain, lungs, and bone and therefore compromise the function of these organs. Given that cancer only really tends to be noticed by patients when it’s already in advanced stages, metastasis has often occurred, thus complicating therapeutic intervention. Drugs that are developed in the clinic are also mainly focused on combatting the primary tumor without addressing those cancer cells that have spread around the body to form metastases. Moreover, targeting the spread of cancer doesn’t help halt metastatic disease. It’s therefore crucial to develop technologies to fight cancer cells that have already spread and seeded organs distant from the one in which the primary tumor developed.”
His research focused on a small class of RNA molecules, called microRNAs (miRNAs), which are known to tune the expression of multiple messenger RNAs that ultimately encode proteins. This means that one miRNA can dampen the levels of hundreds of proteins, themselves involved in very diverse cellular processes such as cell migration, death, division, attachment and so on.
Using a combination of experimental and computational approaches, Nathan found that a miRNA, miR-203, that is known to be important for the regular functioning of human skin and oral mucosa also plays a role in controlling HNSCC metastasis. Specifically, miR-203 is expressed as stem cells commit to become the mature cells that form the outer layers of the skin and oral mucosa. However, in HNSCC, miR-203 expression is lost. If its expression is restored, HNSCC cells are still able to form a tumour that can spread to the lungs (the most common site of metastasis in HNSCC), but cannot efficiently grow once they arrive. Intriguingly, if miR-203 expression is turned on in HNSCC cells that have already begun to grow metastases in the lungs, this results in significantly reduced disease burden.
Nathan also unravels the targets of miR-203 that are responsible for mediating this anti-metastatic effect. The target genes are involved in controlling cell shape, changing the immediate environment in which a cell finds itself and cell metabolism. He says: “Interestingly, these cellular processes controlled by miR-203 are drastically different from those that miR-203 regulates in normal skin and oral mucosa. This suggests that as cancer develops in skin and oral mucosa, not only is the expression of miR-203 shut off, but its function is rewired to perform an entirely different role altogether.”
He adds: “Importantly, I find that human patients with tumuors that express low levels of miR-203 live significantly shorter lives after being diagnosed compared to those few patients whose tumours express higher levels of miR-203. This shows that the findings in this study are clinically relevant and suggest the potential therapeutic advantage of drugs that re-activate miR-203 expression in HNSCC.”
The work was done primarily at the Cancer Research UK Cambridge Institute under the supervision of Professor Fiona Watt who is now at King’s College London. Nathan is currently on the investment team at Playfair Capital, an early-stage venture capital fund which aims to find and back entrepreneurs building disruptive technology to solve global problems.
*Picture of squamous cell carcinoma courtesy of Wiki Commons.












